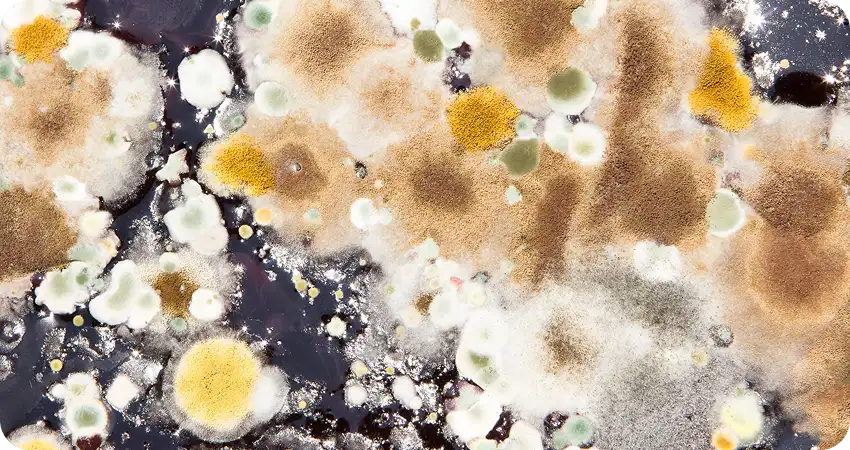
Top-clean

Top 5 Signs It’s Time to Pressure Wash Your South Florida Home

Living in South Florida comes with constant exposure to humidity, salt air, and heavy rain—conditions that lead to rapid buildup of mold, mildew, algae, and grime on your home’s exterior. Over time, this doesn’t just affect curb appeal—it can cause real damage to your siding, roofing, paint, and pavers.
Pressure washing is a practical and necessary solution. It restores the look of your property, protects surfaces from long-term wear, and helps maintain home value. Whether you’re planning to repaint, sell, or simply stay ahead of maintenance, regular exterior cleaning is essential in this climate.
Tropical Pressure Cleaning provides fast, professional pressure washing services across Palm Beach and Martin Counties, using eco-friendly products and expert techniques to deliver long-lasting results. If you’re unsure whether it’s time for a cleaning, here are five clear signs your home needs attention.
Visible Mold, Mildew, or Algae Growth
In South Florida, the warm, humid climate creates ideal conditions for mold, mildew, and algae to thrive, especially in shaded, moist, or poorly ventilated areas around your home. These organic growths aren’t just unsightly; they can also lead to staining, surface deterioration, and even health concerns if left untreated.
You’re most likely to notice mold or algae in areas such as:
- Siding and stucco walls, especially on the north-facing side of the home
- Roof shingles, where dark streaks or green patches often indicate algae colonies
- Driveways and walkways, which may become slippery or discolored from organic buildup
- Pool decks and patios, which are constantly exposed to moisture and heat
Pressure washing is a fast and highly effective solution for removing these contaminants. Using the right amount of pressure and eco-friendly cleaning agents, professionals can kill mold spores and wash away layers of grime without damaging delicate surfaces. Regular cleanings not only improve your home’s appearance but also reduce the risk of long-term damage and slippery conditions.
Discoloration of Driveways, Walkways, or Patios
Over time, the high-traffic surfaces around your home—such as driveways, walkways, and patios—can accumulate layers of dirt, grime, algae, and even motor oil. In South Florida’s damp and sandy climate, it doesn’t take long for these surfaces to lose their brightness and take on a dark, stained appearance. Not only does this impact your home’s curb appeal, but it can also pose a safety hazard when moss or algae create slick, slippery conditions.
Common causes of surface discoloration include:
- Dirt and sand buildup from foot traffic or landscaping runoff
- Motor oil and rust stains on concrete driveways
- Mildew and algae growth in shaded or moisture-prone areas
- Leaf tannins and organic debris from nearby trees or plants
Pressure washing is one of the most effective ways to restore these surfaces. A thorough cleaning removes embedded grime and lifts stains, revealing the original color and texture of your pavers or concrete. Just as important, it eliminates slippery buildup that can increase the risk of falls, especially around pool decks or entryways. Whether you’re preparing for guests or simply want to freshen up your home’s exterior, pressure washing delivers a visible difference you can feel underfoot.

Faded or Dingy Exterior Walls
If your home’s exterior walls are starting to look dull, chalky, or stained, it’s likely due to a combination of South Florida’s intense sun, salty ocean air, and airborne pollutants. These elements gradually break down the surface of your siding or stucco, leaving it faded and dirty-looking, even if the structure itself is still in great shape.
Common environmental factors that contribute to dingy exterior walls include:
- UV exposure, which causes paint and stucco to fade or oxidize over time
- Salt air, which leaves behind a sticky residue that attracts dirt and moisture
- Pollen, dust, and pollution, which settle into textured surfaces and make them appear darker or streaked
Fortunately, pressure washing offers a quick and cost-effective way to refresh your exterior without the need for repainting. The high-pressure rinse removes built-up grime, chalky residue, and surface contaminants, instantly brightening your home’s facade and restoring its color. For textured finishes like stucco, a soft wash technique is often used to avoid surface damage while still delivering a thorough clean. If your walls look tired but you’re not ready for a full paint job, a professional pressure wash may be all you need to bring your home back to life.
Clogged Gutters and Streaky Fascia
Gutters play a vital role in protecting your home from water damage, but in South Florida’s rainy and tree-filled neighborhoods, they can quickly become clogged with leaves, palm fronds, sand, and roof debris. When gutters overflow, they don’t just stop working—they create unsightly streaks along the fascia and siding, and can even lead to water pooling near your foundation or leaking into your home.
Signs that your gutters and fascia need attention include:
- Black streaks or water stains running down the exterior walls
- Sagging or overflowing gutters, especially during rainstorms
- Moss or mildew growth around the roofline and upper siding
- Water runoff is causing erosion or puddling near the base of your home
As part of a seasonal exterior cleaning routine, pressure washing can be used to safely clean fascia boards and flush out grime from the gutter exteriors. While gutter interiors may require manual clearing, pressure washing is ideal for removing dirt, algae, and streaks from the surrounding areas, restoring a crisp and clean appearance. Keeping your gutters and fascia clean not only improves your home’s look, but it also protects it from costly water-related damage.

Preparing for Painting or Selling Your Home
Whether you’re putting your home on the market or planning a fresh coat of paint, pressure washing is an essential first step. Over time, dirt, mold, chalky residue, and pollutants accumulate on exterior surfaces, creating a barrier that prevents paint from properly adhering. Similarly, if you’re preparing to sell, a grimy or weathered exterior can turn away potential buyers before they even step inside.
Pressure washing is especially important in the following situations:
- Before painting, to ensure smooth, long-lasting adhesion on siding, stucco, and trim
- Before staging or photographing the property for real estate listings
- Before open houses, to instantly boost curb appeal and make a strong first impression
- To uncover minor surface issues like cracks or peeling paint that may need touch-ups
A clean exterior communicates that a home has been well-maintained—something every buyer is looking for. It highlights architectural features, makes colors pop, and allows your property to stand out in a competitive market. For homeowners planning to repaint, pressure washing creates the ideal surface for primer and paint, preventing premature peeling or bubbling. Taking this simple step can make a significant difference in both appearance and value.
Pressure Washing: Why It Matters in South Florida
In South Florida’s hot, humid, and coastal environment, pressure washing isn’t just a cosmetic upgrade—it’s an essential part of home maintenance. Regular cleanings help homeowners stay ahead of the region’s fast-growing mold, algae, and dirt buildup while preserving the beauty and integrity of their property. Whether you live inland or near the beach, keeping your exterior surfaces clean can save time, money, and stress in the long run.
Key benefits of pressure washing include:
- Boosting curb appeal, making your home look well-maintained and inviting
- Protecting materials, such as siding, roofing, and pavers, from premature wear or decay
- Reducing long-term maintenance costs by preventing buildup that leads to damage or costly repairs
Not all surfaces can handle the same level of pressure, which is why the right technique matters. Delicate areas like stucco, roof shingles, screen enclosures, and painted wood require a soft-wash approach—low pressure paired with biodegradable cleaning solutions that gently remove algae, mold, and dirt without damaging the surface. In contrast, tougher materials like concrete driveways, paver walkways, patios, and pool decks benefit from high-pressure washing, which effectively breaks down layers of built-up grime, stains, and organic debris.
Tropical Pressure Cleaning uses both soft-wash and high-pressure methods depending on the surface and severity of the buildup. For example, they use soft washing to clean roof tiles without lifting or cracking them, and high-pressure washing to restore the color and safety of heavily trafficked pavers. Serving homes and businesses across Palm Beach and Martin Counties, their team is trained to evaluate each job and apply the safest, most effective solution, always using eco-friendly products that are safe for pets, plants, and surrounding landscaping. In South Florida’s challenging climate, regular pressure washing from a skilled professional like Tropical Pressure Cleaning isn’t just cosmetic—it’s essential protection for your property.
If you’ve noticed mold, discoloration, faded walls, or clogged gutters, it’s likely time to pressure wash your South Florida home. The region’s humid climate makes regular exterior cleaning essential for maintaining curb appeal, preventing surface damage, and protecting your property’s value. Tropical Pressure Cleaning offers expert pressure washing and paver restoration services throughout Palm Beach and Martin Counties, using eco-friendly products and professional techniques tailored to Florida homes. Scheduling a cleaning once or twice a year—especially in spring or fall—can keep your home looking its best year-round. Ready for a refresh? Contact Tropical Pressure Cleaning for fast, reliable service and results you’ll see instantly.
Recent Blog

Eco-Friendly Concrete Cleaning: How We Safeguard Your Lawn and Landscaping
Eco-Friendly Concrete Cleaning: How We Safeguard Your Lawn and LandscapingMaintaining clean concrete surfaces goes beyond aesthetics, especially in South Florida, where heat, humidity, salty air, and heavy rainfall combine to accelerate grime buildup. Driveways,...

How Pressure Washing Clears Years of Buildup from Concrete Surfaces
How Pressure Washing Clears Years of Buildup from Concrete SurfacesConcrete surfaces are essential features of both residential and commercial properties, providing durability and functionality for driveways, sidewalks, patios, pool decks, and parking areas. Over...

The Best Way to Clean Concrete: Why Pressure Washing Beats Store-Bought Cleaners
The Best Way to Clean Concrete: Why Pressure Washing Beats Store-Bought CleanersKeeping concrete surfaces clean is an ongoing challenge, especially in South Florida. Between heat, humidity, salty coastal air, and heavy foot traffic, grime settles deep into driveways,...
Request a Free Quote
Ready to Shine? Get Your Free Quote in a Flash!
Fill out our easy-breezy form and Flash will get back to you faster than a summer storm!
Prefer the old-school way?
Call us at 561.559.6700
